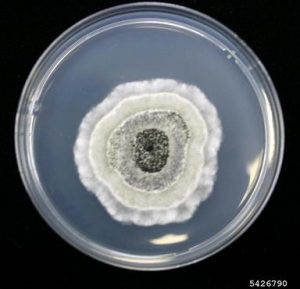
Fungal colony in PDA Source:Rachel Brown, University of Florida, Bugwood.org - Fungal colony in PDASource:Rachel Brown, University of Florida, Bugwood.org

Potato dextrose agar (PDA) is a general-purpose basal medium for identifying, cultivating and enumerating yeast and molds in foods and dairy products. It may also be used to cultivate yeasts and molds from clinical specimens. Since it stimulates sporulation and pigmentation, it also aids in cultivating and differentiating pathogenic and non-pathogenic fungi.
PDA is also useful for maintaining stock cultures of certain dermatophytes. Certain antibiotics or acids like chloramphenicol, tartaric acid and chlortetracycline can be added as selective agents.
Potato dextrose agar with TA (tartaric acid) is recommended for the microbial examination of food and dairy products. Addition of chlortetracycline is recommended for the microbial enumeration of yeast and mold from cosmetics. Potato dextrose agar with chloramphenicol is recommended for the selective cultivation of fungi from mixed samples.
Principle
Potato dextrose agar (PDA) contains dextrose as a carbohydrate source which serves as a growth stimulant and potato infusion provides a nutrient base for the luxuriant growth of most fungi. Agar is added as the solidifying agent. A specified amount of sterile tartaric acid (10%) may be incorporated to lower the pH of the medium to 3.5 so that bacterial growth is inhibited.
Care should be taken not to reheat the acidified medium; heating in the acid state will hydrolyze the agar which can render the agar unable to solidify.
Composition of PDA
*4.0gm of potato extract is equivalent to 200gm of potato infusion
| Ingredients | Gm/L |
|---|---|
| Dextrose | 20 g |
| Potato extract | 4 g* |
| Agar | 15 g |
If supplement added: tartaric acid – 1.4 gm (pH-3.5 +/- 0.3 at 25°C)
Chloramphenicol – 25 mg ( pH-5.6 +/- 0.2 at 25°C)
Chlortetracycline – 40 mg
Procedure for Preparation of media
- Suspend 39 grams of dehydrated media (supplied by commercial suppliers) in 1000 ml of distilled water. Heat to boiling to dissolve the medium completely.
- Sterilize by autoclaving at 15 lbs pressure (121°C) for 15 minutes. Mix well before dispensing.
- In specific work, when pH 3.5 is required, the medium should be acidified with sterile 10% tartaric acid. The amount of acid required for 100 ml. of sterile, cooled medium is approximately 1 ml. Do not heat the medium after the addition of the acid.
- To process the specimen, streak the specimen onto the medium with a sterile inoculating loop to obtain isolated colonies.
- Incubate the plates at 25 – 30°C in an inverted position (agar side up) with increased humidity.
- Cultures should be examined weekly for fungal growth and held for 4 – 6 weeks before being reported as negative.
Result
Yeasts will grow as creamy to white colonies. Molds will grow as filamentous colonies of various colors.
| Fungi | Colony Characteristics | ||||
|---|---|---|---|---|---|
| Texture | Surface color | Reverse color | Zonation | Sporulation | |
| A.candidus | Velvety thick | Creamish white | Slightly creamish | Radially furrowed on the reverse | Moderate |
| A.niger | Velvety | White with typical black spores | Yellow | Heavily furrowed on the reverse | Heavy |
| A.sulphureus | Velvety | Dirty white with yellow spores at the center | Orange to chocolate color | Slightly radially furrowed | Moderate |
| A. versicolor | Floccose | White to orange-cream with green spores at the center | Bright orange | Heavily wrinkled on reverse | Moderate |
| Penicillium corylophilum | Velvety | Dark green | Colorless to Creamish | With shallow centre and radially furrowed raised margin | Moderate |
| P. expansum | Velvety | Dark green with clear exudates and distinct sterile white margin | Yellow | Radially furrowed | Heavy |
| Penicillium spp | Powdery | Olivaceous green with sterile white margin | Orange to red, wrinkled | Radially furrowed | Heavy |
| Fusarium oxysporum | Floccose | Magenta pink | Magenta-red turning violet | With concentric zones of dark and light reddish coloration | Poor |
Typical colony morphology of some fungi
Count the number of colonies and consider the dilution factor (if the test sample was diluted) in determining the yeast and/or mold counts per gram or milliliter of material.
References and further readings
- Acharya T., Hare J. (2022) Sabouraud Agar and Other Fungal Growth Media. In: Gupta V.K., Tuohy M. (eds) Laboratory Protocols in Fungal Biology. Fungal Biology. Springer, Cham. https://doi.org/10.1007/978-3-030-83749-5_2